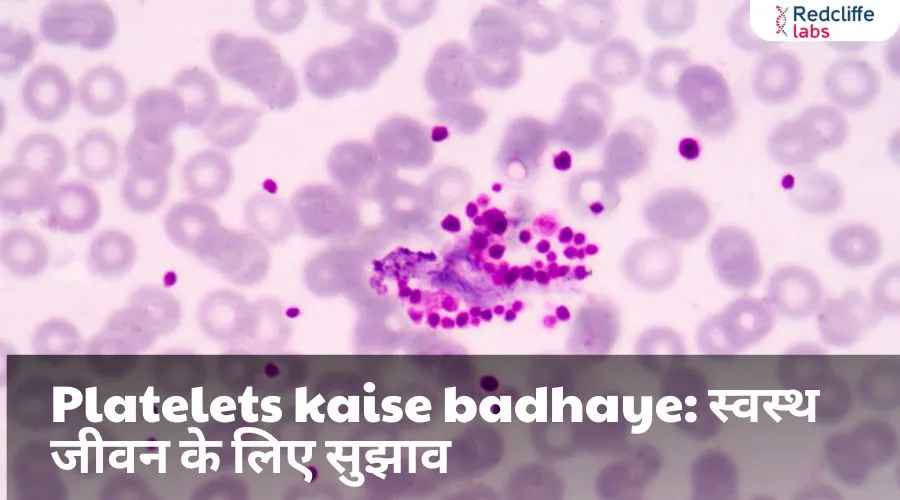
https://myhealth-redcliffelabs.redcliffelabs.com/media/blogcard-images/None/a6216a91-f3e1-48c2-91ed-e0c15da89c8f.webp

Platelets kaise badhaye: स्वस्थ जीवन के लिए सुझाव

Medically Reviewed By
Dr. Geetanjali Gupta
Written By Muskan Taneja
on Oct 29, 2024
Last Edit Made By Muskan Taneja
on Jul 19, 2025
प्लेटलेट्स को ऐसे समझा जाए तो यह कहना बिल्कुल ठीक होगा कि ये हमारे शरीर की रक्षा प्रणाली का अहम हिस्सा हैं। जब भी शरीर में किसी कारण से चोट लगती है या अंदरूनी रक्तस्राव होता है, तो प्लेटलेट्स उस जगह पहुँचकर रक्त को जमाने का कार्य करते हैं। ये छोटे-छोटे रक्त कण होते हैं जो हमारे रक्त में लगातार बहते रहते हैं और रक्तस्राव को रोकने में सहायक होते हैं।
क्या आप जानते हैं कि प्लेटलेट्स की संख्या कम होने से शरीर में क्या-क्या समस्याएं हो सकती हैं? आइए, जानते हैं प्लेटलेट्स को बढ़ाने के तरीके, प्लेटलेट्स कम होने के लक्षण, और कौन-कौन से फल और सब्जियाँ प्लेटलेट्स को बढ़ाने में सहायक हो सकती हैं, प्लेटलेट्स को बनाए रखने के लिए संतुलित आहार और नियमित जीवनशैली का क्या महत्व है। इस ब्लॉग के माध्यम से हम इन सभी सवालों के जवाब जानने की कोशिश करेंगे।
प्लेटलेट्स कैसे बढ़ाएं? ( Platelets kaise badhaye in hindi )
खासकर, डेंगू और अन्य वायरल बुखार में प्लेटलेट्स की कमी का खतरा ज्यादा होता है। आइए जानते हैं कुछ प्राकृतिक उपाय जिनसे आप प्लेटलेट्स की संख्या बढ़ा सकते हैं।
पपीते के पत्तों का रस
पपीते के पत्तों का रस प्लेटलेट्स बढ़ाने के लिए एक बहुत ही असरकारी घरेलू उपाय माना जाता है। रोजाना एक से दो चम्मच इसका रस पीने से प्लेटलेट्स की संख्या तेजी से बढ़ती है।
एलोवेरा का रस
एलोवेरा में कई पौष्टिक तत्व होते हैं जो शरीर को मजबूत बनाते हैं और प्लेटलेट्स की संख्या बढ़ाने में मदद करते हैं। इसे खाली पेट सुबह पिएं।
अनार का सेवन
अनार में एंटीऑक्सीडेंट्स और विटामिन सी होता है, जो प्लेटलेट्स को बढ़ाने में सहायक होता है। रोजाना एक कटोरी अनार खाएं य इसका जूस पिएं।
तुलसी के पत्ते
तुलसी में एंटी-बैक्टीरियल और एंटी-इंफ्लेमेटरी गुण होते हैं, जो इम्यून सिस्टम को मजबूत बनाते हैं। रोजाना तुलसी के कुछ पत्तों को चबाना प्लेटलेट्स बढ़ाने में सहायक होता है।
पौष्टिक आहार लें
प्लेटलेट्स की संख्या को बढ़ाने के लिए विटामिन और मिनरल्स से भरपूर आहार लें। हरी सब्जियां, फलों, सूखे मेवे, और बीन्स को अपनी डाइट में शामिल करें।
गिलोय का रस
आयुर्वेद में गिलोय को इम्यून सिस्टम को मजबूत करने के लिए जाना जाता है। इसका रस प्लेटलेट्स को बढ़ाने में भी लाभकारी है।
कद्दू के बीज
कद्दू के बीजों में विटामिन ए, सी, ई और जिंक होता है जो प्लेटलेट्स की संख्या को बढ़ाने में सहायक होते हैं। रोजाना मुट्ठीभर कद्दू के बीज खाएं।
हाइड्रेटेड रहें
पर्याप्त मात्रा में पानी पीना शरीर के लिए बहुत जरूरी है। पानी खून को पतला बनाए रखने में मदद करता है जिससे प्लेटलेट्स की संख्या बढ़ाने में सहायता मिलती है।
प्रोटीन का सेवन
शरीर में प्रोटीन की पर्याप्त मात्रा प्लेटलेट्स के निर्माण में मदद करती है। अंडे, दूध, और मछली जैसे प्रोटीन युक्त आहार का सेवन करें।
तनाव को कम करें
अत्यधिक तनाव से भी प्लेटलेट्स पर नकारात्मक प्रभाव पड़ता है। ध्यान, योग और गहरी सांस लेने की तकनीकों से तनाव को कम करने में मदद मिलती है।
प्लेटलेट्स कम होने के लक्षण ( Symptoms of low platelets )
प्लेटलेट्स (थ्रोम्बोसाइट्स) की कमी, जिसे थ्रोम्बोसाइटोपेनिया कहा जाता है, कई स्वास्थ्य समस्याओं का संकेत हो सकती है। निम्नलिखित लक्षण प्लेटलेट्स की कमी के हो सकते हैं:
खून बहना: नाक से खून बहना, मसूड़ों से खून निकलना या अत्यधिक ब्रूज़िंग (चोट लगने पर नीले धब्बे) होना।
अत्यधिक थकान: अचानक से थकान महसूस करना, जो सामान्य गतिविधियों को भी कठिन बना सकता है।
त्वचा पर दाग: शरीर के विभिन्न हिस्सों पर लाल या भूरे रंग के छोटे धब्बे (पेटेचiae) जो खून के छोटे थक्कों के कारण होते हैं।
कभी-कभी खून की कमी: हल्का या असामान्य रूप से तेज़ खून आना, जैसे कि मासिक धर्म के दौरान अधिक खून आना।
चक्कर आना या हल्का-फुल्का होना: अचानक से चक्कर आना या हल्का महसूस करना, खासकर जब खड़े होते हैं।
खून के थक्के जमने में कठिनाई: यदि आप चोट लगने पर सामान्य से अधिक समय लेते हैं तो यह प्लेटलेट्स की कमी का संकेत हो सकता है।
जल्दी-जल्दी जख्म लगना: अगर छोटी-छोटी चोटों पर भी अधिक खून निकलता है या जख्म जल्दी नहीं भरते हैं।
अतिरिक्त शरीर के अंगों में सूजन: जैसे कि टांगों, हाथों या अन्य क्षेत्रों में सूजन।
असामान्य मनोबल या मानसिक स्थिति: कई बार मानसिक स्थिति में परिवर्तन जैसे चिड़चिड़ापन या उदासी भी हो सकते हैं।
प्लेटलेट्स बढ़ाने वाले फल और सब्जियाँ: जानें कौन-कौन से खाद्य पदार्थ हैं फायदेमंद
हमारा इम्यून सिस्टम प्लेटलेट्स के स्तर को बनाए रखने में महत्वपूर्ण भूमिका निभाता है। लेकिन, कई बार बीमारियों या कमजोरी की वजह से प्लेटलेट्स की संख्या कम हो जाती है। इस स्थिति में, कुछ फल और सब्जियाँ प्लेटलेट्स को नेचुरली बढ़ाने में सहायक हो सकती हैं। आइए जानते हैं, किन-किन चीज़ों को अपनी डाइट में शामिल कर प्लेटलेट्स के स्तर को सुधारा जा सकता है:
- पपीता और पपीते के पत्ते
पपीता न केवल स्वादिष्ट होता है, बल्कि प्लेटलेट्स बढ़ाने में भी सहायक होता है। इसमें मौजूद एंजाइम्स प्लेटलेट्स के उत्पादन में मदद करते हैं। पपीते के पत्तों का रस पीने से भी तेजी से लाभ मिलता है। - अनार
आयरन और विटामिन्स से भरपूर अनार प्लेटलेट्स बढ़ाने में कारगर होता है। इसके रोजाना सेवन से शरीर में खून की कमी दूर होती है और प्लेटलेट्स का स्तर बढ़ता है। - किवी
किवी में विटामिन C और K भरपूर मात्रा में होते हैं, जो इम्यून सिस्टम को मजबूत बनाते हैं और प्लेटलेट्स को बढ़ाने में मदद करते हैं। - पालक
पालक में आयरन और फोलिक एसिड होता है, जो खून के लिए बहुत फायदेमंद है। इसके सेवन से प्लेटलेट्स का उत्पादन बढ़ता है और शरीर को ऊर्जा मिलती है। - चुकंदर और गाजर
चुकंदर और गाजर के जूस का सेवन प्लेटलेट्स को बढ़ाने के लिए बहुत ही फायदेमंद होता है। इनमें मौजूद एंटीऑक्सीडेंट्स प्लेटलेट्स की संख्या को तेजी से बढ़ाते हैं। - एलोवेरा जूस
एलोवेरा जूस शरीर में डिटॉक्सिफिकेशन कर प्लेटलेट्स को नेचुरली बढ़ाता है। रोजाना थोड़ी मात्रा में एलोवेरा जूस का सेवन शरीर को लाभ पहुँचाता है। - ब्रोकोली
ब्रोकोली विटामिन K का अच्छा स्रोत है, जो खून के थक्के बनने में सहायक होता है और प्लेटलेट्स को बढ़ाने में मददगार साबित होता है।



